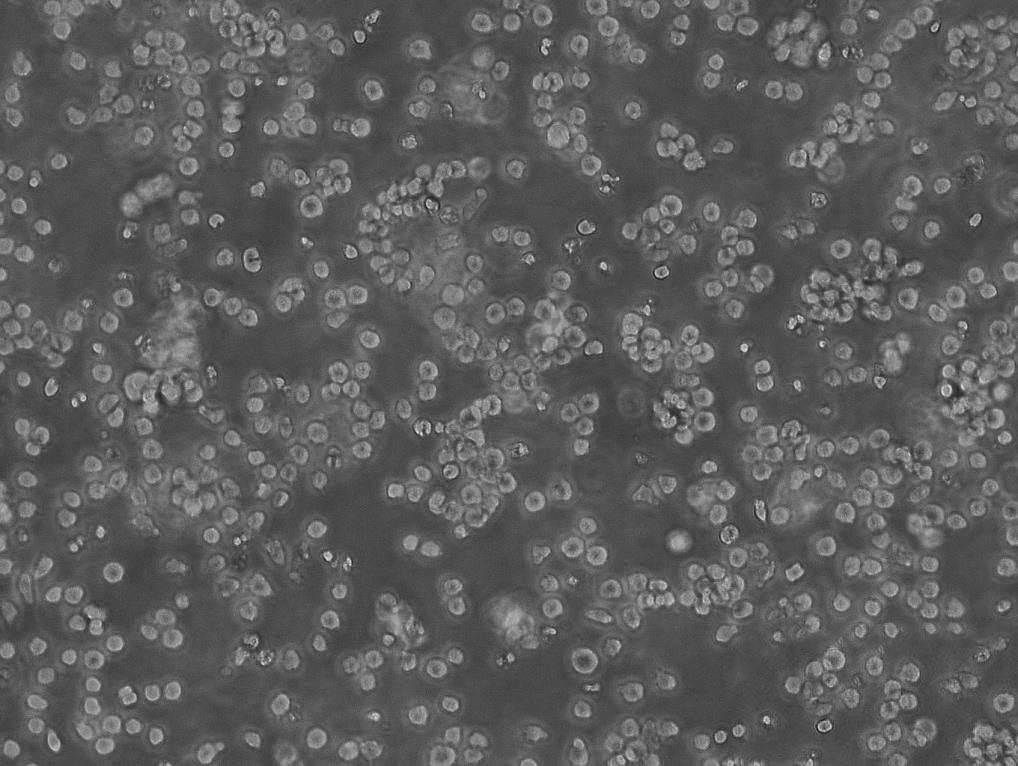
U-251-MG Cells#人神经胶质瘤细胞系源头种子库|培养基|STR图谱

"U-251-MG Cells#人神经胶质瘤细胞系源头种子库|培养基|STR图谱
换液周期:每周2-3次
生长特性:贴壁
背景信息:U-251 MG分离至一位患者的胶质母细胞瘤组织。
在实验室细胞培养过程中,细胞聚集是一个常见的问题,它可能会影响细胞的正常生长、实验结果的准确性等诸多方面。为了防止细胞聚集,科研人员通常会采用多种有效的方法。首先,合适的细胞培养容器表面处理至关重要。许多细胞培养瓶和培养皿会经过特殊的表面处理,例如用亲水性的聚合物涂层。减少细胞之间因为吸附在同一位置而聚集的可能性。酶处理也是常用的手段之一。在细胞消化传代过程中,使用适量的胰蛋白酶等酶试剂。胰蛋白酶能够分解细胞间的连接蛋白,使细胞彼此分离。但是,酶的浓度和处理时间需要严格把控。如果酶浓度过高或者处理时间过长,虽然细胞能够很好地分散,但可能会对细胞造成损伤,影响细胞的活性。以常见的哺乳动物细胞为例,一般使用0.25%的胰蛋白酶,在37℃下处理1-3分钟,就可以有效地将细胞分散开,同时又能保证细胞的健康状态。添加合适的试剂也是防止细胞聚集的有效策略。一些抗聚集剂如乙二胺四乙酸(EDTA)被广泛使用。EDTA能够螯合细胞培养液中的钙、镁离子,而这些离子是细胞间连接所依赖的重要成分。当它们被螯合后,细胞间的连接就会变弱,从而减少聚集。在细胞培养过程中,轻柔的操作也不容忽视。无论是在细胞的接种、换液还是转移过程中,避免剧烈摇晃或吹打。通过这些综合的方法,实验室能够更好地防止细胞聚集,为细胞系培养实验的成功提供保障。
SW-780 Cells;背景说明:详见相关文献介绍;传代方法:1:2-1:3传代;每周换液2-3次。;生长特性:贴壁或悬浮,详见产品说明书部分;形态特性:详见产品说明书;相关产品有:U-251 MG细胞、Kasumi 1细胞、ID8细胞
SW1417 Cells;背景说明:详见相关文献介绍;传代方法:1:2—1:4传代,每周换液1-2次;生长特性:贴壁生长;形态特性:上皮细胞;相关产品有:B-16细胞、Kuramochi细胞、L细胞
HR8348 Cells;背景说明:详见相关文献介绍;传代方法:1:2-1:3传代;每周换液2-3次。;生长特性:贴壁或悬浮,详见产品说明书部分;形态特性:详见产品说明书;相关产品有:DHL10细胞、LS174T细胞、DMS153细胞
MIA Paca2 Cells;背景说明:详见相关文献介绍;传代方法:1:2传代;;生长特性:贴壁生长;形态特性:详见产品说明书;相关产品有:HUT-28细胞、rRTEC细胞、BL2141细胞
┈订┈购(技术服务)┈热┈线:1┈3┈6┈4┈1┈9┈3┈0┈7┈9┈1【微信同号】┈Q┈Q:3┈1┈8┈0┈8┈0┈7┈3┈2┈4;
产品包装:复苏发货:T25培养瓶(一瓶)或冻存发货:1ml冻存管(两支)
传代比例:1:2-1:4(首次传代建议1:2)
如何进行细胞复苏:1)从容器中取出冻存管,直接浸入37℃温水中,并不时摇动令其尽快融化;2)从37℃水浴中取出冻存管,打开盖子,用吸管吸出细胞悬,加到离心管并滴加10倍以上培养,混匀;3)离心,1000rpm,5min;4)弃去上清,加入含10%小牛血清培养重悬细胞,计数,调整细胞密度,接种培养瓶,37℃培养箱静置培养;5)次日更换一次培养,继续培养。【温馨提醒】1)从增殖期到形成致密的单层细胞以前的培养细胞都可以用于冻存,但ZuiHAO为对数生长期细胞。在冻存前一天ZuiHAO换一次培养;2)将冻存管放入容器或从中取出时,要做HAO防护工作(戴棉手套),以免冻伤;3)冻存和复苏ZuiHAO用新配制的培养。细胞复苏的时候,有些初次实验员将冻存管从中取出后,放在室温下,经常发生冻存管爆炸,该怎么避免出现这种情况吗?其中在拧紧冻存管的时候是否有哪些细节要注意的?一般常用的方法是取出冻存管后在超净工作台中用酒精棉球擦试管口,再稍拧松盖子,再放37度水浴锅中摇溶,在将细胞转移到装有37度预热过的培养基的试管中,迅速离心,再用培养基洗一遍。
来源说明:细胞主要来源ATCC、ECACC、DSMZ、RIKEN等细胞库
P3.653 Cells;背景说明:详见相关文献介绍;传代方法:1:2-1:3传代;每周换液2-3次。;生长特性:贴壁或悬浮,详见产品说明书部分;形态特性:详见产品说明书;相关产品有:Ect1/E6E7细胞、Stanford University-Diffuse Histiocytic Lymphoma-2细胞、H446细胞
P3.653 Cells;背景说明:详见相关文献介绍;传代方法:1:2-1:3传代;每周换液2-3次。;生长特性:贴壁或悬浮,详见产品说明书部分;形态特性:详见产品说明书;相关产品有:Ect1/E6E7细胞、Stanford University-Diffuse Histiocytic Lymphoma-2细胞、H446细胞
NRK49F Cells;背景说明:肾;成纤维细胞;自发永生;传代方法:1:2-1:3传代;每周换液2-3次。;生长特性:贴壁;形态特性:详见产品说明书;相关产品有:SN4741细胞、GM04678细胞、3T3-L1 ad细胞
HMVEC Cells;背景说明:微血管;内皮 Cells;传代方法:1:2-1:3传代;每周换液2-3次。;生长特性:贴壁;形态特性:详见产品说明书;相关产品有:NCI H226细胞、MCF12A细胞、H4细胞
SW1222 Cells;背景说明:详见相关文献介绍;传代方法:1:2-1:3传代;每周换液2-3次。;生长特性:贴壁或悬浮,详见产品说明书部分;形态特性:详见产品说明书;相关产品有:HRA 19细胞、Normal Rat Kidney-49F细胞、HCC941122细胞
物种来源:人源、鼠源等其它物种来源
U-251-MG Cells#人神经胶质瘤细胞系源头种子库|培养基|STR图谱
形态特性:成纤维细胞样
┈订┈购(技术服务)┈热┈线:1┈3┈6┈4┈1┈9┈3┈0┈7┈9┈1【微信同号】┈Q┈Q:3┈1┈8┈0┈8┈0┈7┈3┈2┈4;
DSMZ菌株保藏中心成立于1969年,是德国的国家菌种保藏中心。该中心一直致力于细菌、真菌、质粒、抗菌素、人体和动物细胞、植物病毒等的分类、鉴定和保藏工作。DSMZ菌种保藏中心是欧洲规模最大的生物资源中心,保藏有动物细胞500多株。Riken BRC成立于1920年,是英国的国家菌种保藏中心。该中心一直致力于细菌、真菌、植物病毒等的分类、鉴定和保藏工作。日本Riken BRC(Riken生物资源保藏中心)是全球三大典型培养物收集中心之一。Riken保藏中心提供了很多细胞系。在世界范围内,这些细胞系,都在医学、科学和兽医中具有重要意义。Riken生物资源中心支持了各种学术、健康、食品和兽医机构的研究工作,并在世界各地不同组织的微生物实验室和研究机构中使用。
44FT0 Cells(提供STR鉴定图谱)
Abcam Jurkat PRG2 KO Cells(提供STR鉴定图谱)
Am Coo Cells(提供STR鉴定图谱)
BayGenomics ES cell line RRK122 Cells(提供STR鉴定图谱)
BayGenomics ES cell line XL142 Cells(提供STR鉴定图谱)
CaHo-06 Cells(提供STR鉴定图谱)
DA00513 Cells(提供STR鉴定图谱)
DA06024 Cells(提供STR鉴定图谱)
GM00469 Cells(提供STR鉴定图谱)
NS1-Ag 4/1 Cells;背景说明:这是P3X63Ag8(ATCCTIB-9)的一个不分泌克隆。Kappa链合成了但不分泌。能抗0.1mM8-氮杂鸟嘌呤但不能在HAT培养基中生长。据报道它是由于缺失了3-酮类固醇还原酶活性的胆固醇营养缺陷型。检测表明肢骨发育畸形病毒(鼠痘)阴性。;传代方法:1:2传代,3天内可长满。;生长特性:悬浮生长;形态特性:淋巴母细胞;相关产品有:Meat Animal Research Center-145细胞、AMO-1细胞、ESC细胞
HCAEC Cells;背景说明:冠状动脉;内皮 Cells;传代方法:1:2-1:3传代;每周换液2-3次。;生长特性:贴壁;形态特性:详见产品说明书;相关产品有:NCIH522细胞、H.Ep.-2细胞、PLC细胞
SupB15WT Cells;背景说明:详见相关文献介绍;传代方法:1:2传代。3天内可长满。;生长特性:悬浮生长;形态特性:淋巴母细胞;相关产品有:H-1944细胞、IGROV 1细胞、ME 180细胞
BEL7404 Cells;背景说明:用Northernblot方法,未能检测到细胞中1.3kbLFIRE-1/HFREP-1mRNA的表达。;传代方法:消化3-5分钟。1:2。3天内可长满。;生长特性:贴壁生长;形态特性:上皮细胞样;相关产品有:Detroit562细胞、LNCaP FGC细胞、SACC83细胞
MBT-2 Cells;背景说明:膀胱移行细胞癌;C3H/He;传代方法:1:2-1:3传代;每周换液2-3次。;生长特性:贴壁;形态特性:详见产品说明书;相关产品有:HEY-A8细胞、HT-1376细胞、EC109细胞
Uhth-74 Cells;背景说明:未分化甲状腺癌;女性;传代方法:1:2-1:3传代;每周换液2-3次。;生长特性:贴壁;形态特性:详见产品说明书;相关产品有:HOS (TE85, Clone F5)细胞、P30-OHK细胞、OSKM-1细胞
Nthy-ori 3.1 Cells;背景说明:甲状腺;SV40转化;女性;传代方法:1:2-1:3传代;每周换液2-3次。;生长特性:贴壁;形态特性:详见产品说明书;相关产品有:CL 1-5细胞、LLC-PK(1)细胞、IPEC1细胞
U-251-MG Cells#人神经胶质瘤细胞系源头种子库|培养基|STR图谱
Medical University of Graz-Chordoma 1 Cells;背景说明:骶骨脊索瘤;女性;传代方法:1:2-1:3传代;每周换液2-3次。;生长特性:贴壁;形态特性:详见产品说明书;相关产品有:HEH2细胞、CA46细胞、B95-8细胞
C41 Cells;背景说明:宫颈鳞癌;女性;传代方法:1:2-1:3传代;每周换液2-3次。;生长特性:贴壁;形态特性:详见产品说明书;相关产品有:HEK293-A细胞、C2A细胞、EMT6细胞
RA Cells;背景说明:详见相关文献介绍;传代方法:1:2-1:3传代;每周换液2-3次。;生长特性:贴壁或悬浮,详见产品说明书部分;形态特性:详见产品说明书;相关产品有:T47D细胞、NCIH2291细胞、MV522细胞
HT clone H9 Cells;背景说明:H9细胞是HUT78(ATCCTIB161)的克隆系(Callo,RC,etal)。细胞表面带有CD3、CD4标记。研究表明,该细胞系对人体免疫缺陷病毒(HIV-1)敏感,可用于检测、分离和增殖HIV-1,也可用于其它人类Tcell病毒的研究。;传代方法:1:3传代,2-3天传一代;生长特性:悬浮生长;形态特性:淋巴母细胞样;相关产品有:AsPC-1细胞、KU-19-19细胞、NCI-H2081细胞
HCC1806 Cells;背景说明:该细胞源自一位患有乳腺髓样癌的44岁黑人女性,表达WNT7B癌基因,细胞与细胞边界处有细胞桥粒、微绒毛、张力细丝。;传代方法:1:2-1:3传代;每周换液2-3次。;生长特性:贴壁生长;形态特性:上皮样;相关产品有:OVCA420细胞、GM03569细胞、COV-434细胞
HCEC Cells;背景说明:角膜;上皮 Cells;传代方法:1:2-1:3传代;每周换液2-3次。;生长特性:贴壁;形态特性:详见产品说明书;相关产品有:HARAB细胞、VSC4.1细胞、B104 [Rat neuroblastoma]细胞
MDA-MB-468 Cells;背景说明:该细胞是1977年由CailleauR等从一位患有转移性乳腺癌的51岁黑人女性的胸腔积液中分离得到的。虽然供体组织的G6PD等位基因杂合,但此细胞株始终表现为G6PDA表型。P53基因273位密码子存在G→A突变,从而导致Arg→His替代。每个细胞上存在1×106个EGF受体。;传代方法:1:2-1:4传代;2-3天换液1次;生长特性:贴壁生长;形态特性:上皮样;相关产品有:V79-4细胞、H82细胞、Ra No. 1细胞
NCI/ADR-RES Cells;背景说明:详见相关文献介绍;传代方法:1:2-1:3传代;每周换液2-3次。;生长特性:贴壁或悬浮,详见产品说明书部分;形态特性:详见产品说明书;相关产品有:FM-88细胞、DC 2.4细胞、L-cell细胞
┈订┈购(技术服务)┈热┈线:1┈3┈6┈4┈1┈9┈3┈0┈7┈9┈1【微信同号】┈Q┈Q:3┈1┈8┈0┈8┈0┈7┈3┈2┈4;
MOVAS Cells;背景说明:主动脉平滑肌;SV40转化;C57BL/6;传代方法:1:2-1:3传代;每周换液2-3次。;生长特性:贴壁;形态特性:详见产品说明书;相关产品有:SUM159PT细胞、KHYG细胞、M-O7e细胞
Homo sapiens No. 578, breast cells Cells;背景说明:乳腺 Cells;传代方法:1:2-1:3传代;每周换液2-3次。;生长特性:贴壁;形态特性:详见产品说明书;相关产品有:TMK-1细胞、Ramos.2G6.4C10细胞、COLO 206F细胞
F442A Cells;背景说明:脂肪前体细胞;雄性;Swiss albino;传代方法:1:2-1:3传代;每周换液2-3次。;生长特性:贴壁;形态特性:详见产品说明书;相关产品有:TO 175.T细胞、H23细胞、SN12-PM6细胞
HSC-6 Cells;背景说明:口腔鳞癌;传代方法:1:2-1:3传代;每周换液2-3次。;生长特性:贴壁;形态特性:详见产品说明书;相关产品有:PC3M-2B4细胞、OVCAR.8细胞、Ca Ski细胞
SO-Rb 50 Cells;背景说明:视网膜母细胞瘤;女性;传代方法:1:2-1:3传代;每周换液2-3次。;生长特性:悬浮;形态特性:详见产品说明书;相关产品有:293/EBNA细胞、H-1385细胞、RASMC细胞
SN12C-PM6 Cells;背景说明:肾癌;男性;传代方法:1:2-1:3传代;每周换液2-3次。;生长特性:贴壁;形态特性:详见产品说明书;相关产品有:NBL-5细胞、SK-N-FI细胞、Strain KB细胞
Line 697 Cells;背景说明:B淋巴细胞白血病;男性;传代方法:1:2-1:3传代;每周换液2-3次。;生长特性:悬浮;形态特性:详见产品说明书;相关产品有:HUT 226细胞、L-cells细胞、HeLa-S3细胞
DLD 1 Cells;背景说明:DLD-1是1977-1979年间D.L.Dexter和同事分离的两株结直肠腺癌细胞株中的一株。在ATCC和其它地方进行的DNAfingerprinting和染色体组型分析表明这株细胞与HCT-15(CCL-225)相似,说明这两者是来自同一个人的不同克隆。他们的遗传起源可通过DNAfingerprinting证实,但染色体组型分析显示它们缺乏染色体标记一致改变或数目上一致改变。细胞的CSAp阴性(CSAp-)。DLD-1细胞的p53抗原表达呈阳性(p53抗原产生了一个C->;传代方法:消化5分钟。1:2。4-5天长满。;生长特性:贴壁生长;形态特性:上皮细胞样;相关产品有:PC-3细胞、MCF-12A细胞、NK-92 transfected with MFG-hIL2细胞
Jurkat77 Cells;背景说明:详见相关文献介绍;传代方法:1:2-1:3传代;每周换液2-3次。;生长特性:贴壁或悬浮,详见产品说明书部分;形态特性:详见产品说明书;相关产品有:HCEC细胞、P3.times.63 Ag8.653细胞、H766T细胞
HuH6 Cells;背景说明:肝癌。据说产球蛋白和甲胎蛋白。;传代方法:消化3-5分钟。1:2。6-7天长满。;生长特性:贴壁生长;形态特性:上皮样;相关产品有:Mel526细胞、LC1细胞、Wistar Institute, Susan Hayflick细胞
2T Cells;背景说明:骨肉瘤;女性;传代方法:1:2-1:3传代;每周换液2-3次。;生长特性:贴壁;形态特性:详见产品说明书;相关产品有:HEK-293A细胞、rUCMSCs细胞、NCM460细胞
MRASMC Cells;背景说明:详见相关文献介绍;传代方法:1:2-1:3传代;每周换液2-3次。;生长特性:贴壁或悬浮,详见产品说明书部分;形态特性:详见产品说明书;相关产品有:Tohoku Hospital Pediatrics-1细胞、EC9706细胞、CCD-18Co细胞
NK-10A Cells;背景说明:1967年,该细胞系KleinE和KleinG建系,源于一名16岁患有Burkitt's淋巴瘤的黑人男性,beta-2-微球蛋白阴性,表达EBNA,VCA,sIg。该细胞携带EB病毒,是一个典型的B淋巴母细胞系,可用于白血病发病机制的研究。;传代方法:1:2传代;生长特性:悬浮生长;形态特性:淋巴母细胞样;相关产品有:X63细胞、EFO 27细胞、LL/2(LLc1)细胞
GM12782 Cells(提供STR鉴定图谱)
HAP1 FAM111A (-) 2 Cells(提供STR鉴定图谱)
HAP1 YAP1 (-) 2 Cells(提供STR鉴定图谱)
HK1 Cells(提供STR鉴定图谱)
iPS-TIG975-e2 Cells(提供STR鉴定图谱)
MC1 Cells(提供STR鉴定图谱)
ND11351 Cells(提供STR鉴定图谱)
PluriStem C57BL/6N Cells(提供STR鉴定图谱)
ShB05 Cells(提供STR鉴定图谱)
Ubigene A-549 CAMKK2 KO Cells(提供STR鉴定图谱)
UOK109 Cells(提供STR鉴定图谱)
2B7-7 Cells(提供STR鉴定图谱)
NCIH1436 Cells;背景说明:详见相关文献介绍;传代方法:随细胞的密度而增加;生长特性:悬浮生长;形态特性:详见产品说明书;相关产品有:RD-ES细胞、NR8383细胞、HLEC细胞
HIT clone T15 Cells;背景说明:胰岛β细胞;SV40转化;传代方法:1:2-1:3传代;每周换液2-3次。;生长特性:贴壁;形态特性:详见产品说明书;相关产品有:NL20细胞、SVEC4-10细胞、NW-38细胞
MGSMC Cells;背景说明:详见相关文献介绍;传代方法:1:2-1:3传代;每周换液2-3次。;生长特性:贴壁或悬浮,详见产品说明书部分;形态特性:详见产品说明书;相关产品有:WM 115细胞、Hs675细胞、16HBE14o-细胞
SKN-AS Cells;背景说明:详见相关文献介绍;传代方法:1:5-1:10传代;每周换液2-3次。;生长特性:贴壁生长;形态特性:上皮样;相关产品有:NCI-H1238细胞、Glioma-261细胞、Earle's L cells细胞
NCI-H2085 Cells;背景说明:详见相关文献介绍;传代方法:1:3-1:6传代 ;生长特性:贴壁生长;形态特性:上皮细胞;相关产品有:L-6细胞、H-7721细胞、HT55细胞
MDA MB 175 VII Cells;背景说明:该细胞源自一位54岁患有乳腺导管癌白人女性的胸腔积液。;传代方法:1:2—1:6传代,每周换液2—3次;生长特性:松散贴壁生长;形态特性:上皮细胞样;相关产品有:Ontario Cancer Institute-Acute Myeloid Leukemia-5细胞、H-1623细胞、TO 175.T细胞
H-187 Cells;背景说明:经典小细胞肺癌;胸腔积液转移;男性;传代方法:1:2-1:3传代;每周换液2-3次。;生长特性:悬浮;形态特性:详见产品说明书;相关产品有:Hs27F细胞、MDA-MB468细胞、JTC-39细胞
Case 3 Cells;背景说明:详见相关文献介绍;传代方法:1:2传代;生长特性:贴壁生长;形态特性:上皮样;相关产品有:NCIH2106细胞、BGC823细胞、H1666细胞
AM38 Cells;背景说明:详见相关文献介绍;传代方法:1:2传代;生长特性:贴壁生长;形态特性:上皮细胞;相关产品有:RPMI8226/S细胞、VMRCLCD细胞、Co 205细胞
BLO-11 Cells;背景说明:详见相关文献介绍;传代方法:1:2-1:3传代;每周换液2-3次。;生长特性:贴壁或悬浮,详见产品说明书部分;形态特性:详见产品说明书;相关产品有:3T3-Swiss细胞、MCF 7B细胞、16HBE细胞
GM07404A Cells;背景说明:详见相关文献介绍;传代方法:1:2传代;生长特性:贴壁生长 ;形态特性:详见产品说明书;相关产品有:SNU407细胞、HTori-3细胞、CTLL(2)细胞
Bowes melanoma cells Cells;背景说明:详见相关文献介绍;传代方法:1:6—1:10传代,2天换液1次;生长特性:贴壁生长;形态特性:上皮细胞;相关产品有:HCC-1187细胞、Panc327细胞、QGY-7701细胞
EPC Cells;背景说明:详见相关文献介绍;传代方法:1:2-1:3传代;每周换液2-3次。;生长特性:贴壁或悬浮,详见产品说明书部分;形态特性:详见产品说明书;相关产品有:M059J细胞、SPCA1细胞、HCC1419细胞
Bowes melanoma cells Cells;背景说明:详见相关文献介绍;传代方法:1:6—1:10传代,2天换液1次;生长特性:贴壁生长;形态特性:上皮细胞;相关产品有:HCC-1187细胞、Panc327细胞、QGY-7701细胞
LNCaP subline C4-2 Cells;背景说明:前列腺癌;左锁骨上淋巴结转移;男性;传代方法:1:2-1:3传代;每周换液2-3次。;生长特性:贴壁;形态特性:详见产品说明书;相关产品有:Swiss3T3细胞、SK_HEP1细胞、CHO/dhFr-细胞
EBC-1/original Cells;背景说明:肺鳞癌;皮肤转移;男性;传代方法:1:2-1:3传代;每周换液2-3次。;生长特性:贴壁;形态特性:详见产品说明书;相关产品有:Caki-2细胞、ACC-3细胞、AN-3细胞
MCF-12F Cells;背景说明:乳腺上皮细胞;女性;传代方法:1:2-1:3传代;每周换液2-3次。;生长特性:贴壁;形态特性:详见产品说明书;相关产品有:COLO-741细胞、FHL 124细胞、GRSL细胞
G361-mel Cells;背景说明:详见相关文献介绍;传代方法:1:2-1:4传代,2-3天换液1次。;生长特性:贴壁生长;形态特性:上皮细胞;相关产品有:KBM-5细胞、TK-1细胞、REC 1细胞
L929(NCTC) Cells;背景说明:详见相关文献介绍;传代方法:1:2-1:3传代;每周换液2-3次。;生长特性:贴壁或悬浮,详见产品说明书部分;形态特性:详见产品说明书;相关产品有:C-26细胞、GP-293细胞、AHH1细胞
L929(NCTC) Cells;背景说明:详见相关文献介绍;传代方法:1:2-1:3传代;每周换液2-3次。;生长特性:贴壁或悬浮,详见产品说明书部分;形态特性:详见产品说明书;相关产品有:C-26细胞、GP-293细胞、AHH1细胞
NCI-Hut 125 Cells;背景说明:腺鳞状肺癌;男性;传代方法:1:2-1:3传代;每周换液2-3次。;生长特性:贴壁;形态特性:详见产品说明书;相关产品有:R1800[RA]细胞、NMCG-1细胞、Strain V细胞
NCIH187 Cells;背景说明:经典小细胞肺癌;胸腔积液转移;男性;传代方法:1:2-1:3传代;每周换液2-3次。;生长特性:悬浮;形态特性:详见产品说明书;相关产品有:J774.A1细胞、CMT.64细胞、HMEC1细胞
SH-SY5Y Parental Cells;背景说明:据报道,该细胞的密度可高达1×106cells/cm2,具有中等水平的多巴胺β羟化酶的活性。;传代方法:1:2传代;生长特性:贴壁生长;形态特性:上皮样;相关产品有:KYSE-70细胞、YD38细胞、Calu6细胞
SW 954 Cells;背景说明:详见相关文献介绍;传代方法:1:3-1:6传代,2-3天换液1次。;生长特性:贴壁生长;形态特性:上皮细胞;相关产品有:A375-S2细胞、Mel526细胞、SUIT 2细胞
J774A1 Cells;背景说明:详见相关文献介绍;传代方法:1:2-1:3传代;每周换液2-3次。;生长特性:贴壁或悬浮,详见产品说明书部分;形态特性:详见产品说明书;相关产品有:H676细胞、OVCAR 432细胞、CaEs17细胞
NCI-H-128 Cells;背景说明:小细胞肺癌;胸腔积液转移;男性;传代方法:1:2-1:3传代;每周换液2-3次。;生长特性:贴壁;形态特性:详见产品说明书;相关产品有:RPMI 8226/S细胞、NRK-49F细胞、C-127细胞
Hs695T Cells;背景说明:详见相关文献介绍;传代方法:1:2-1:4传代,2-3天换液1次。;生长特性:贴壁生长;形态特性:上皮细胞;相关产品有:Rat Basophilic Leukemia-1细胞、COLO320/DM细胞、SUPM2细胞
P3X63Ag8 Cells;背景说明:详见相关文献介绍;传代方法:1:2-1:3传代;每周换液2-3次。;生长特性:贴壁或悬浮,详见产品说明书部分;形态特性:详见产品说明书;相关产品有:HEK293A细胞、SCC-7细胞、SNU407细胞
BALB 3T3 clone A31 Cells;背景说明:胚胎;成纤维;自发永生;雄性;BALB/c;传代方法:1:2-1:3传代;每周换液2-3次。;生长特性:贴壁;形态特性:详见产品说明书;相关产品有:MG-63细胞、PL45细胞、TM-3细胞
SRS-82 Cells;背景说明:详见相关文献介绍;传代方法:1:2-1:3传代;每周换液2-3次。;生长特性:贴壁或悬浮,详见产品说明书部分;形态特性:详见产品说明书;相关产品有:BIC-1细胞、MDA-MB415细胞、UMNSAH-DF-1细胞
LU165 Cells;背景说明:详见相关文献介绍;传代方法:1:2-1:3传代;每周换液2-3次。;生长特性:贴壁或悬浮,详见产品说明书部分;形态特性:详见产品说明书;相关产品有:WIL2-S细胞、hMSC-BM细胞、HCT 116细胞
┈订┈购(技术服务)┈热┈线:1┈3┈6┈4┈1┈9┈3┈0┈7┈9┈1【微信同号】┈Q┈Q:3┈1┈8┈0┈8┈0┈7┈3┈2┈4;
HEI-193 Cells;背景说明:神经鞘瘤;男性;传代方法:1:2-1:3传代;每周换液2-3次。;生长特性:贴壁;形态特性:详见产品说明书;相关产品有:HNSC细胞、NIH:OVCAR-5细胞、NCI-H1819细胞
SNU-C2A Cells;背景说明:详见相关文献介绍;传代方法:每周两次换液;生长特性:松散附着、多单元的聚合;形态特性:上皮细胞样;相关产品有:AAV293细胞、SNU-354细胞、SNU-5细胞
U-251-MG Cells#人神经胶质瘤细胞系源头种子库|培养基|STR图谱
SL-29 Cells;背景说明:胚成纤维细胞; White Leghorn SPAFAS;传代方法:1:2-1:3传代;每周换液2-3次。;生长特性:贴壁;形态特性:详见产品说明书;相关产品有:MB39细胞、Namalwa细胞、HCC95细胞
MDA-MB231 Cells;背景说明:MDA-MB-231来自患有转移乳腺腺癌的51岁女病人的胸水。在裸鼠和ALS处理的BALB/c小鼠中,它能形成低分化腺癌(III级)。;传代方法:消化3-5分钟,1:2,3天内可长满;生长特性:贴壁生长;形态特性:上皮样;相关产品有:SF-126细胞、HMEL细胞、AN-3细胞
COLO-320HSR Cells;背景说明:该细胞1984年建系,源自一位33岁患有大肠腺癌男性经5-fu治疗后的腹水。;传代方法:1:2传代。3天内可长满。;生长特性:半贴壁生长;形态特性:详见产品说明书;相关产品有:UACC-812细胞、Hs 940.T细胞、CHP212细胞
MB49 Cells;背景说明:膀胱癌;雄性;C57BL/Icrfa(t);传代方法:1:2-1:3传代;每周换液2-3次。;生长特性:贴壁;形态特性:详见产品说明书;相关产品有:PL-5细胞、Hx-147细胞、HeLa细胞
HCC1588 Cells;背景说明:肺鳞癌;女性;传代方法:1:2-1:3传代;每周换液2-3次。;生长特性:贴壁;形态特性:详见产品说明书;相关产品有:A2780/Taxol细胞、Hs-606-T细胞、KB细胞
BayGenomics ES cell line CSJ140 Cells(提供STR鉴定图谱)
BayGenomics ES cell line SYA416 Cells(提供STR鉴定图谱)
CCRC-M102 Cells(提供STR鉴定图谱)
M1/75.16.4.HLK Cells(提供STR鉴定图谱)
RenCa-IL2 Cells(提供STR鉴定图谱)
RWE01 Cells(提供STR鉴定图谱)
"